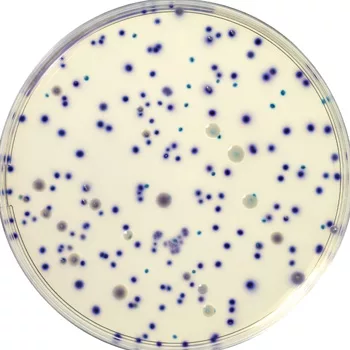

Food and Dairy Lab Finds Rapid E. coli Test Easier To Use
When food processors outsource their microbiological testing, they rely on third party facilities to quickly and accurately assess the safety of their products and environment. Most processors put finished products on hold while they wait for test results, chipping away at the shelf life and freshness of each item. When testing facilities can speed up that process, while still ensuring the highest levels of accuracy and quality, it is a win-win situation for the client and the lab. That’s why many labs are replacing traditional testing methods for certain bacteria with faster and easier-to-use alternatives that are currently hitting the market.
For example, at a food, dairy and water testing laboratory located on the West Coast that has used an film-based enumeration test for its E. coli testing for years, the Food Microbiology Group decided that it was time for a change. The lab performs a wide variety of tests for food spoilage organisms and pathogens in food for its clients, including carcass swabs and pathogen testing on finished products. The A2LA-accredited facility relies on rapid technologies to deliver quick results and state-of-the-art Good Laboratory Practices (GLP) to assure their accuracy.
Last year, the facility’s lab supervisor began searching for an alternative E. coli test that would deliver fast clear results that would be easier to read than traditional testing methods.
“The test we were using had its limits,” says the testing lab supervisor. “Gas in the background makes it difficult to confirm and to separate what is a colony and what is an air pocket.”
Adding to the challenges of reading the test was the fact that if the countable range of colonies on the film was above 50, it became too crowded to count. “Sometimes the colonies grow too close together and along with the gas pockets it becomes hard to see what’s what. It all just looks like pinpoint dots,” she says, noting that this required the lab to retest the sample to confirm results, an extra step that also added to the wait time for clients.
These testing challenges caused her to rethink her testing program.
At about that time she received an agar-based E. coli test kit sample from Bio-Rad Laboratories, Inc., a multinational manufacturer and distributor of life science research products and clinical diagnostics (www.bio-rad.com). The RAPID’E. coli 2TM test is a selective chromogenic medium used for direct enumeration of E. coli and other coliform bacteria in food products. It has been granted Performance Tested Method status by the AOAC Research Institute (Certificate # 050601).
“It was perfect timing,” she says of receiving the sample. “We had this test so I tried it, and I liked it.”
Faster, Cheaper, Easier to Use
Before she could evaluate the benefits of using the faster test, her first goal was to determine whether it was accurate and reliable. She was pleased with the initial results. The RAPID’E. coli 2 presents with clearly defined color schemes, allowing technicians to easily read results at a glance, and the test results were accurate and clear.
With its effectiveness proven, she was able to compare the pros and cons of each test method. She determined that the RAPID’E. coli 2 test was faster, the results were easier to decipher, and it was a more cost-effective choice.
The RAPID’E. coli 2 test delivers results in 24 hours, half the time of the previously used test method. “Getting results a day earlier is good,” she says, noting that for certain clients, such as those who do regular carcass swabs, the faster she gets results, the quicker they have the data necessary to make processing decisions. “When it comes to bacteria, they want to know the results as soon as possible.”
The principle of the chromogenic medium is based on simultaneous detection of two enzymatic activities: B-D-glucuronidase (GLUC) and B-D-galactosidase (GAL). The medium contains two chromogenic substrates: one substrate specific to GAL that induces blue-green coloration of colonies positive for this enzyme, and one substrate specific to GLUC that induces pink violet coloration of colonies positive for this enzyme. Coliforms (GAL+/GLUC) form blue to green colonies, whereas specifically; E. coli (GAL+/GLUC+) form violet to pink colonies. GLUC detection gives the culture medium a high specificity. E. coli is in fact one of the only species of Enterobacteriae to possess this enzyme.
“If technicians see the violet or pink colonies, they know E. coli is present,” she says. “It is just easier to read.” And that means it’s easier to get the laboratory’s food and dairy company customers the rapid, accurate test results they need to release top-quality products to consumers with the highest level of confidence possible and without sacrificing shelf life or freshness.
She also likes that fact that the RAPID’E. coli 2 test has a countable range of 15 to 150 colonies, which is more than she was able to achieve with her previous test. “If we can see many more colonies per milliliter, that enables us to get a more accurate picture of bacteria present,” she says.
That accuracy is critical for everyone in the lab, which prides itself on quality and reliability. “When you detect bacteria on a test, you need to be sure you are right because a mistake that results in a major recall could be very costly.”
The experience of using the Bio-Rad Laboratories RAPID’E. coli 2 test convinced her that a chromogenic medium is a superior testing method. “It’s accurate, and for us, accuracy is the most important thing.”
bio-rad.com
Looking for quick answers on food safety topics?
Try Ask FSM, our new smart AI search tool.
Ask FSM →








